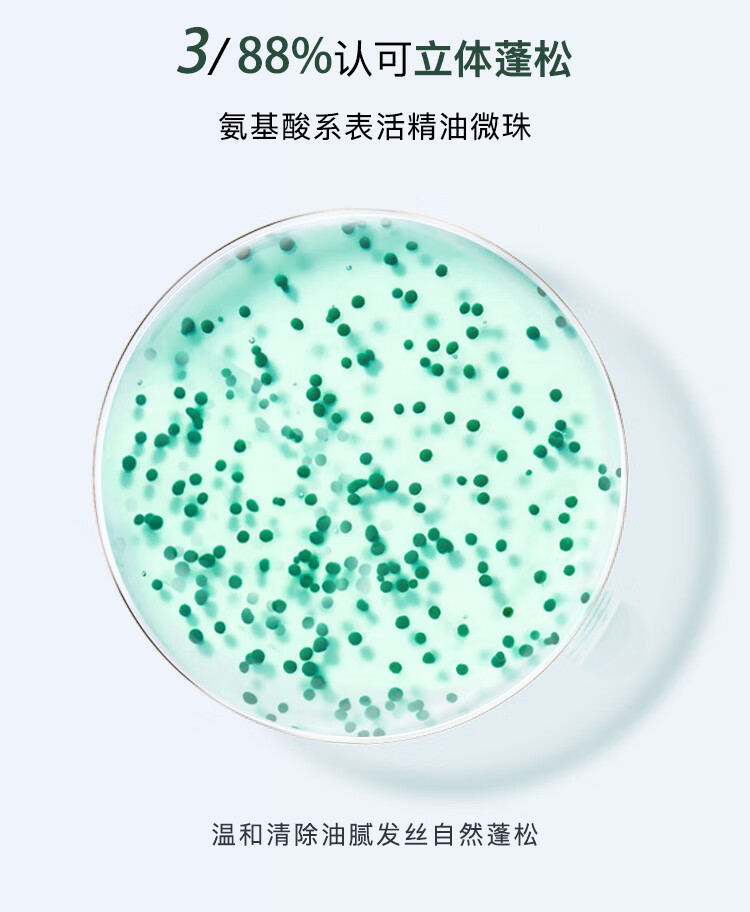

馥绿德雅(RENE FURTERER)赋活焕能控油洗发露600ml(控油强韧 清爽无硅油 防断掉发)法国
¥348.00
| 运费: | ¥ 8.00-25.00 |
| 库存: | 105 件 |
商品详情

- 大德生优选 (微信公众号认证)
- 北京和太大德生商贸有限公司拥有丰富的商品资源和行销经验,用心汇聚全国最优质的产品,为广大消费者提供纯天然、无污染、0添加的原产地产品,让消费者吃的放心,用的安心,为更多的人分享健康美好生活!
- 扫描二维码,访问我们的微信店铺
- 随时随地的购物、客服咨询、查询订单和物流...